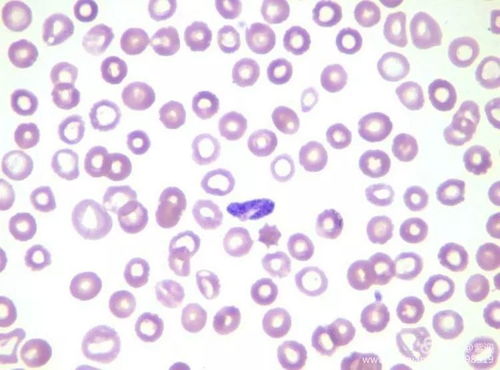
先天梅毒是什么样的 先天梅毒是什么样的

先天梅毒是什么样的
与生俱来的疾病,如同隐匿的阴霾,自生命的曙光中便悄然而至。当人们谈及“先天梅毒”这一令人痛心的疾病时,不禁让人联想到它给孩子和家庭带来的沉重负担。今天,就让我们一起深入了解这一病症。
先天梅毒,一个让人闻之色变的词汇。每当它与孩子联系在一起时,无疑给无数家庭带来了深重的打击。这是父母通过遗传传递给孩子的一种疾病,让孩子在生命的最初阶段便承受了梅毒的侵袭。
早期先天梅毒,通常在生后的两年内显现。孩子会呈现出全身症状,皮肤变得松弛苍白,仿佛老人的皮肤一般。他们体重增长缓慢,哭声低弱嘶哑。还会出现发热、贫血等特定病症。皮肤粘膜损害是此阶段最常见的症状,其形态多样,如红斑、丘疹、水疱或脓疱等。这些病症与后天梅毒的二期皮疹相似,但也有其独特之处,特别易于发生在手掌、足跖及腔洞周围。
除此之外,口角、鼻孔、肛周这些部位也可能会出现线状皲裂性损害。当它们愈合后,会形成特征的放射状疤痕。外阴及肛门处可能会发生类似于扁平湿疣的损害。梅毒性鼻炎是最常见的早期症状之一,它可能导致流涕、鼻塞,使婴儿哺乳困难。还可能引发喉炎,导致声音嘶哑。甚至可能引发骨软骨炎、骨膜炎、甲沟炎及甲床炎等。
如果新生儿出现一期梅毒的症状,很可能是因为通过有梅毒病损的产道感染所致。而晚期先天梅毒则是在生后两年以上发病,其损害性质与后天梅毒的三期损害相似,表现为对皮肤、粘膜、骨骼及内脏等的广泛损害。
每一个患病的孩子都是家庭的珍宝,先天梅毒的侵害无疑是对孩子和家庭的一种巨大挑战。希望每一个家庭都能得到足够的关爱与支持,共同面对这一困境。让我们携手努力,为孩子们的未来撑起一片蓝天,让他们远离疾病的阴霾,健康快乐地成长。
在此,我们也要提醒广大读者,关注身体健康,加强预防意识。对于已经患病的孩子,更要给予他们足够的关爱和支持,帮助他们勇敢地面对病魔,战胜困难。毕竟,每一个生命都值得被珍视和尊重。
